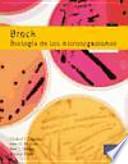
Libro Brock, biología de los microorganismos 12/e

Lo Esencial en Cuidados Paliativos
Sinopsis del Libro

This book is an adaptation and translation from English into Spanish of, "Essentials in Hospice and Palliative Care: A Practical Resource for Every Nurse; ISBN: 9781926923116 " It provides an engaging 'delicious and digetible' (easy-to-read, understand and apply) compendium of practical facts, ideas, instructions and procedures to meet the competencies needed by every nurse who works with patients and families who are dealing with any life-limiting illness or condition across all settings.
Ficha Técnica del Libro
Subtitulo : Un recurso práctico en enfermería
Número de páginas 316
Autor:
- Katherine Murray
Categoría:
Formatos Disponibles:
PDF, EPUB, MOBI
¿Cómo descargar el libro?
Aquí te presentamos diversas opciones para adquirir el libro.
Valoración
4.1
18 Valoraciones Totales